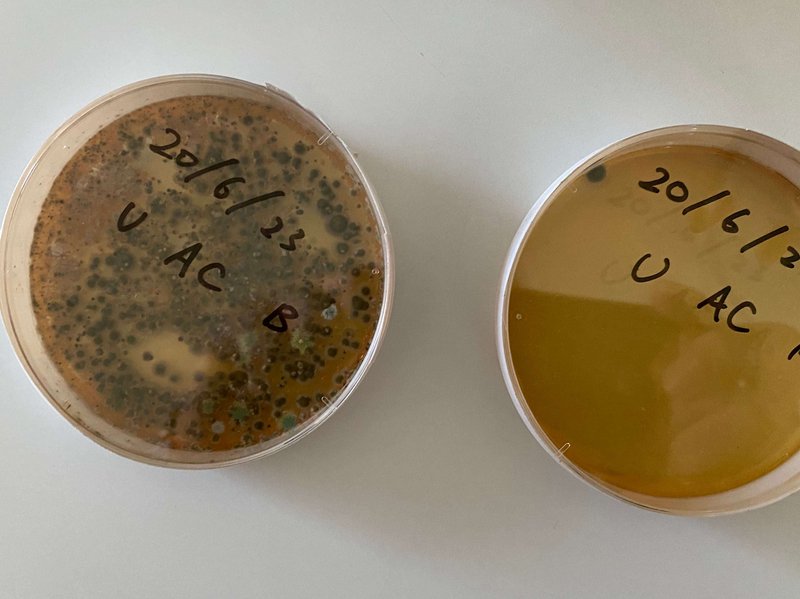

”バイオのエアコン洗浄”しませんか?
バイオテクノロジーによるエアコン洗浄は
健康を支えるナチュラルクリーニング
日本では春から夏に掛けてエアコン洗浄を業者に依頼するのは、電気代の節約やカビ臭対策、水漏れや冷却の効きが弱くなった時に分解洗浄します。
しかし、エアコンの清掃と消毒は、部屋の定期的な清掃と同じくらい重要な掃除なのです。

空気を快適に調整するエアコン。先ずはフィルターから掃除しないと、あきらめて放置した瞬間に逆効果が起きます。そして、フィルターお掃除機能は、良いことよりも害をもたらします。ほこり、花粉、カビ胞子がお掃除機能内に蓄積し、病原菌やカビがエアコン内部で繁殖します。もちろん、そこには浮遊するウイルスも含まれ、これらすべてが空気とともに部屋の中を循環し始めます。そのような住環境で仕事や生活している人の健康を守れるでしょうか?
新型コロナウイルス感染を始め感染症の患者は年々増加の一途を辿っています。健康状態が悪ければ、当然に人は頻繁に病気になり、仕事を休んで病院にも通います。その時間とコストは高すぎました!
ハウスクリーニングや特殊清掃の専門業者は、抗菌や抗カビ、抗ウイルスを科学的アプローチで解決するバイオセーフティの専門ではないので、次亜塩素など化学薬品を使用して殺菌することはできても、病原菌やカビ(真菌)の防除はできません。私たちは代わりに、定期的な”バイオのエアコン洗浄”で完全な抗菌処置を行う”バイオのエアコン洗浄”をお勧めします。
我慢や犠牲は一切なしの”ナチュラルクリーニング”
エアコン洗浄だけに限らず、100%天然成分で掃除する「ナチュラルクリーニング」に対して、私たちは安全の代わりに、化学石油洗剤に比べて便利さや汚れ落ちが劣るイメージを抱いてしまい、我慢や犠牲があると思い込んでいませんか?
石鹸には固形だけでなく便利な液体もあり、油には強アルカリではなく微生物から生まれた酵素の有機分解力によって解決できる様になりました。さらに、抗菌や抗カビ、抗ウイルスも日本のバイオテクノロジーによって確立されました。もう、ナチュラルクリーニングで我慢や犠牲にすることは何もありません。

私たちは”バイオの掃除”によって洗剤に対する意識を変えれます。
私たちのバイオ洗剤の成分には、単一の微生物から分泌される酵素の中から発見された特別な抗菌活性物質が含まれています。
現在、その抗菌活性物質の解析は、病原菌、カビ、ウイルスを含む64種類の抗菌(不活化)検証を終えています。
この検証内容は、薬機法の元「消毒」という単語は使用できませんが、消毒と同等以上の効果を、化学薬品ではない100%天然成分のナチュラルクリーニングで達成する、アフターコロナにふさわしい革新的な掃除方法です。
出張バイオのエアコン洗浄の様子はコチラから

時として忘れがちですが、世界発の抗生物質「ペニシリン」もアオカビから抽出された天然由来物質です。
少し視点を変えると大幅な節約です
”バイオのエアコン洗浄”は、従来の目的の省エネに加え、その部屋で常に生活や仕事をしている人の健康を目的とし、治療費や休養の時間が少なくなることを意味します。
日本国内の清掃業者さんと提携して”バイオの掃除”を提供しています。
あなたの家や職場でも検討されたい場合には問い合わせください。

お問い合わせ クリーンアップファクトリー㈱
この記事が気に入ったらサポートをしてみませんか?
